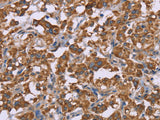
Cyclophilin F Polyclonal Antibody Store at -20°C

Cyclophilin F Polyclonal Antibody Store at -20°C
SKU: E-AB-11115-200
Cyclophilin F Polyclonal Antibody Store at -20°C
| SKU # | E-AB-11115 |
| Reactivity | Human, Mouse, Rat |
| Host | Rabbit |
| Applications | WB, IHC |
Product Details
| Isotype | IgG |
| Host | Rabbit |
| Reactivity | Human, Mouse, Rat |
| Applications | WB, IHC |
| Clonality | Polyclonal |
| Immunogen | Recombinant protein of human PPIF |
| Abbre | Cyclophilin F |
| Synonyms | CYP3, CyP M, Cyclophilin 3, Cyclophilin F, Cyp D, CypD, Mitochondrial cyclophilin, Peptid, Peptidyl prolyl cis trans isomerase, Peptidyl-prolyl cis-trans isomerase F, cyclophilin D, hCyP3, mitochondral, mitochondrial |
| Swissprot | |
| Calculated MW | 22 kDa |
| Cellular Localization | Mitochondrion matrix. |
| Concentration | 0.4 mg/mL |
| Buffer | Phosphate buffered solution, pH 7.4, containing 0.05% stabilizer and 50% glycerol. |
| Purification Method | Affinity purification |
| Research Areas | Cancer, Cell Biology, Metabolism, Immunology, Signal Transduction |
| Conjugation | Unconjugated |
| Storage | Store at -20°C Valid for 12 months. Avoid freeze / thaw cycles. |
| Shipping | The product is shipped with ice pack,upon receipt,store it immediately at the temperature recommended. |
Related Reagents
| Applications | Recommended Dilution |
| WB | 1:500-1:2000 |
| IHC | 1:100-1:300 |
Background
The protein encoded by this gene is a member of the peptidyl-prolyl cis-trans isomerase (PPIase) family. PPIases catalyze the cis-trans isomerization of proline imidic peptide bonds in oligopeptides and accelerate the folding of proteins. This protein is part of the mitochondrial permeability transition pore in the inner mitochondrial membrane. Activation of this pore is thought to be involved in the induction of apoptotic and necrotic cell death.